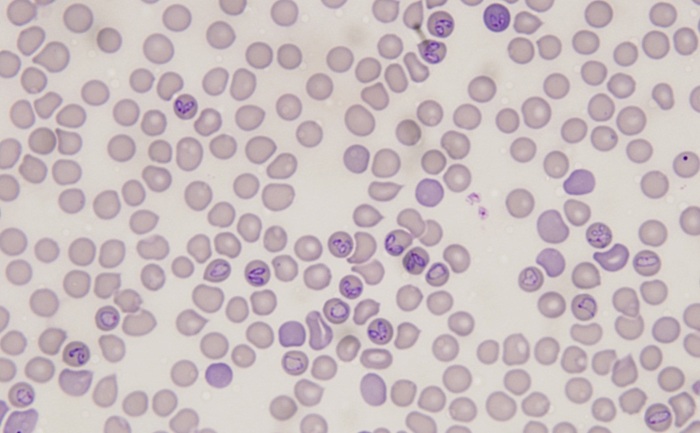

Знакомый прислал интересный материал об обработке собак противоклещевыми средствами. Прочитав, я поняла, что 12 лет неправильно обрабатывала своих собак, следуя инструкции на упаковке. Может кому-то еще эта информация будет полезна.
P.S. не реклама, ибо никакого отношения к нижеперечисленным торговым маркам я не имею (без их названия я не вижу способа сохранить смысл поста), орфография автора сохранена, пост без рейтинга.
Почему многие схемы противоклещевой обработки оказываются не действенны и защита пробивает?
1) Не правильно применяют. Сперва мы капаем капли! Их наносят точечно вдоль позвоночника, я наношу в шахматном порядке по обе стороны от хребта до самого хвоста. И еще две точки на шее и на груди, но нельзя давать слизывать. Чем больше собака, тем больше точек нанесения. На крупную собаку не менее 3 точек, по одной на каждые 10 кг живого веса. При правильной обработке, шерсть собаки не должна быть влажной и не должно быть видно масляных пятен. За три дня до нанесения капель и три дня после - мыть/ купаться нельзя. Это связно с тем, что капли должны методом диффузии оказаться в подкожной клетчатки и там равномерно распределиться вдоль всего тела. Наносить капли надо строго на кожу, а не на шерсть и не лить всю пипетку только на холку. Так же надо помнить, что первые два-три дня после нанесения вещества собака наиболее уязвима. Не водите ее в лес и не везите сразу на дачу, обрабатывайте загодя!
Спрей начинает действовать через четыре часа, ошейник через пару дней.
Капли надо перекапывать раньше указанного срока, особенно в пиковые месяцы и при поездках на дачу/загородном проживании, примерно на 21-24 день. Всегда отмечайте дату обработки! Барс рекомендуют перекапывать раз в 14 дней. Особенно в мае/сентябре.
Ошейник от блох и клещей одевается через неделю после капель и никогда не снимается, он сидит плотно - так чтобы лишь один палец пролезал и не под основным, а на расстоянии не менее 2 см от него, ближе к ушкам. С кожаным ошейником капли и спец.ошейник лучше не сочетать, так как кожа имеет пористую структуру и способна впитывать вещества при соприкосновении с ее поверхностью. Если вы носите именно кожаный ошейник - не одевайте его сверху защитного и не носите в первые два дня после нанесения капель. Килтикс (ошейник) перед первым надеванием и раз в месяц надо прощелкивать по кругу пальцами и потянуть за концы, Скалибур рекомендуют раз в месяц протереть чуть-влажной тряпочкой для активации действующего вещества.
Не жалейте капли - не растягивайте их, четко берите по весу , для каждой собаки - свой вес и своя пипетка! Если вес собаки находится между пипетками, берите большую.
2) Капли надо сочетать с ошейником, а перед лесом в самый клещевой пиковый период дополнительно обрабатывать собаку спреем. Основным средством защиты остаются именно капли. Ошейники плохо защищают собаку. Если у вас только ошейник, меняйте его чаще - раз в 3,5-4 месяца. В среднем при сочетании с каплями Килтикса хватает на 4-5 месяцев, Форесто на 5-6, то есть два ошейника на сезон в регионах, где неблагоприятная обстановка по клещам.
3) Используйте вещества с разным составом из разных групп и с различным механизмом действия (репелленты, инсектоакарициды, контактные). Не используйте капли и ошейник одной марки, даже если продавец будет говорить обратное.
4) На данный момент из капель чаще всего пробивают: Адвантикс, Фронтлайн (если он используется один), Рольф клуб (особенно старая формула), в последнее время стал пробивать даже проверенный годами Барс (после смены состава). Если вы на них, усиливайте их действие хорошим ошейником и спреем.
На данный момент лучшим спреем считается Больфо, но при этом он дольно токсичен - применяйте его лишь перед походом в лес в пиковые месяца. Он не влагостойкий и его действие уменьшается после купания и под воздействием солнечных лучей. Спрей наносят на кожу, против роста волоса так, чтобы шерсть стала чуть влажной. Особенно тщательно обрабатывают пах, живот, бока, лапы и хвост и шею. На морду не брызгают, а наносят вещество перчаткой, закрыв рот и глаза. Не используйте спрей чаще, чем раз в неделю. Наибольшая потребность в спрее есть в пиковые месяцы, после мытья собаки в первые 2-3 дня, перед походом в лес, на речку и поездки за город, а так же после купания в реке, но всегда на сухую кожу. Максимальная концентрация спрея начинается через 4 часа после нанесения. Он не влагостойкий и довольно токсичный, вне периода клещевой активности (апрель-май и конец августа-сентябрь) его стоит использовать лишь в походе или перед прогулкой в лес.
5) Капли: Адвокат, Адвантейдж, Стронгхолд НЕ ДЕЙСТВУЮТ на иксодовых клещей - основных переносчиков бабезий!
6) Из ошейников по отзывам на разных форумах за последние два года чаще пробивают: все ошейники на натуральных маслах, Хартц, Больфо, Беафар.
Хорошие капли по отзывам: Прак- тик, Вектра 3Д, Хартц, Фронтлайн комбо в сочетании с другими средствами, Рольф клуб 3Д в сочетании с другими способами защиты, Фронтлайн три акт (но о последнем пока мало данных), Фиприст, Инспектор, многие по сей день применяют Брас, но он довольно аллергичный и жесткий препарат. Если вы много купаетесь и бываете на солнце, внимательно читайте аннотацию - не все капли одинаковы. На данный момент можно отметить Прак-тик, как наиболее устойчивые капли к воздействию воды и солнечных лучей.
7) Меняйте капли в течение сезона, но в пик используйте проверенные. Даже надежные схемы следует менять, они устаревают, клещи к ним привыкают. Покупайте капли лишь в крупных сетях, остерегайтесь подделок. Часто подделывают Фронтлайн комбо.
8) Не доверяйте одному средству защиты, если вы часто выезжаете на природу.
Хорошие ошейники, в сочетании с каплями/спреем: Килтикс, Форесто, Скалибур.
Сейчас самый надежный ошейник - Форесто. Но не доверяйте только ему, особенно в самый пик - май и сентябрь.
Спрей - лишь дополнительная защита перед лесом, после купания, перед поездкой на дачу. В пиковые месяцы им следует перекрывать действие капель с 15дня, но не наносить чаще, чем раз в неделю.
9)Регулярно осматривайте и прочесывайте. Особенно живот, шею, подмышки, пах, хвост, морду, лапы и подушечки. Клещ ползает долго, заражает не сразу же после впивания. Купите средство для выкручивания клещей.
Мое мнение такого, самой работающей схемой является Прак-тик раз в 21 день, Форесто и спрей Больфо перед лесом и поездкой на дачу. А так же регулярный методичный осмотр и прочесывание шерсти и подшерстка с помощью пуходерки и железной расчески с частыми мелкими зубчиками, называемой "блохоловка" .
10) Очень часто я слышу о понятие пробивания препарата, используемом не корректно. Надо хорошо понимать, пробивание - это когда собака, обработанная каким-либо способом или средством внешней защиты, заболевает пироплазмозом. А не то, что клещ сел или укусил, я на такие мелочи давно перестала обращать внимания. Дело в том, что на данный момент не существует ни одного репеллента от иксодовых клещей с доказанным эффектом. Большинство современных средств защиты сочетают в себе контактное и акаридидное свойство. Это значит, что клещ в любом случае сядет, но при соприкосновении с кожей будет получать яд через лапки, который делает собаку "не вкусной", а при длительном соприкосновении - парализует его - эффект обожженных лапок. Но самым эффективным средством остаются инсектоакарицидные препараты, действующие после укуса и блокирующие ГАМК зависимые рецепторы, что нарушает передачу импульсов к нервным окончаниям и ведет к параличу и смерти. Заражение бабеозизом происходит не в момент укуса и первые 24 часа наименее безопасны, лишь на 2 сутки напившийся клещ исторгает излишки крови и слюны с бабезиями обратно в ранку, по принципу обратного поршня. Так что у нас есть время снять не успевшего напиться клеща, а у препарата есть время его уничтожить. Я порой снимаю по несколько десятков клещей, даже впившихся, но ни разу не заболели, значит защита не пробила. Место укуса надо обработать антисептиком и 10-14 дней следить за состоянием, регулярно измеряя температуру. Нести сразу клеща на анализ смысла нет, их практически нигде не принимают и нужен именно живой клещ. А сдавать анализ с собакой имеет смысл не ранее 3 дня после снятия клеща или при первых симптомах болезни. Обратите внимание, что помимо классической картины болезни - отказ от еды, вялость, кровь в моче, в последнее время все чаще встречается атипичная форма и хронический бабезиоз, где картина сильно смазана.
Случаи бессимптомного или не явного пироплазмоз второй год шагают по нашим весям. Когда Ричик был еще щенком, мы попали в клинику с инфекцией, но предварительный диагноз был именно "нетипичный пироплазмоз". В очереди было полно собак со схожими симптомами, позже у них подтвердился диагноз "бабезиоз". Ни у одной не было плохого аппетита и потемнения мочи, лишь вялость, температура, проблема с задними лапами. Поэтому я для себя вывод сделала, сняв впившегося клеща или в пик активности: апрель-май/ конец августа -сентябрь , надо быть особенно внимательными к питомцу. Инкубационный период может быть и несколько дней и пару недель. Аппетит вообще не показатель, малоежки могут отказываться от еды из-за жары, влюбленности, дачных приключений, вы потеряете бдительность. А едоки будут продолжать есть и уже заболев. Смотрите на температуру, никаких "потрогали нос", только мерять раз в день. Приближение к 39,5-40 и выше - повод немедленного обращения в клинику. Малейшее нарушение в поведение должно насторожить - вялость, сонливость, чуть приволакивает ногу, неловкость при спрыгивании/ запрыгивании на диван или кресло, изменение питьевого режима - много или мало пьет, чуть бледные десна, скорее устает и ищет тень, послабление - стул желто- оранжевого оттенка, отказ от угощения или игры, слабость. То играет, то вдруг ложится, на прогулке плетется сзади.
Не ждите крови в моче. Если есть подозрение, свозите на анализ. На ранней стадии достаточно одного укола Пиро- стопа и пробиотики, на более поздней капельницы с физ-раствором, Рингером, препаратами для поддержания сердца и почек, вит В и потом пробиотики и гепапротекторы -гептрал/гепа-мерц. Не вводите глюкозу.
Нет 100 % средств защиты от клещей, поэтому главной защитой остается регулярный осмотр и бдительность хозяина.
Здоровья любимым хвостикам!
И. Видус, 03.05.2016 года.